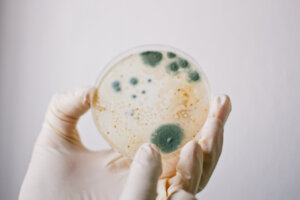

How-to articles
Practical advice to help you solve specific air quality issues at home.
Data-led studies
Original research on air quality issues from our data science team.
Opinion pieces
Thoughts, analysis and discussion of topics that matter to our readers.